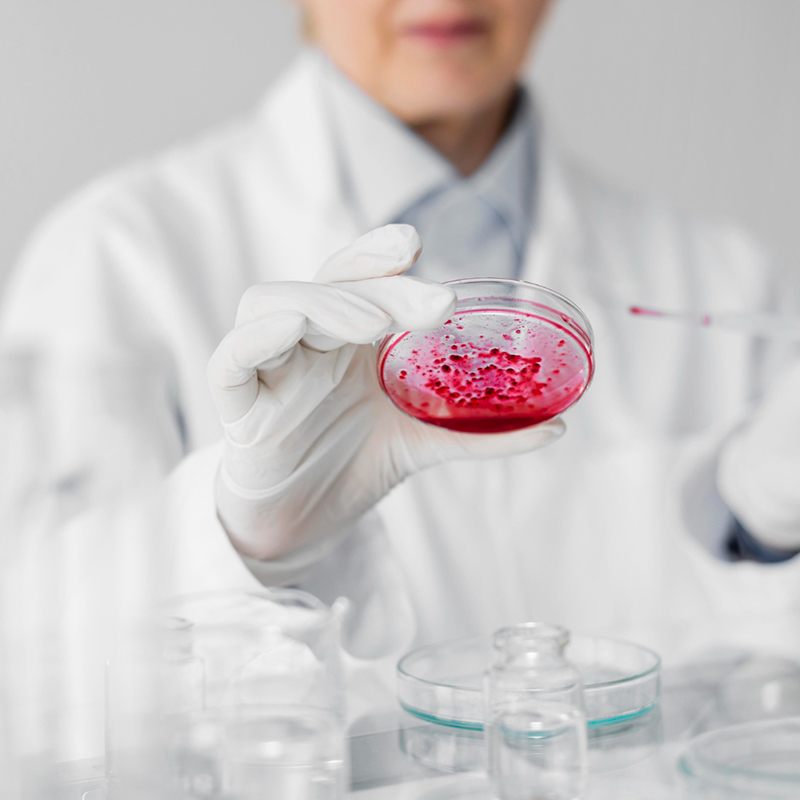

เมื่อใกล้ถึงวันต้อนรับสมาชิกใหม่ คุณพ่อคุณแม่ทุกคนต่างก
Category Archives: สเต็มเซลล์กับการรักษาโรค
หลักประกันสุขภาพจากของขวัญชิ้นแรก ในฐานะพ่อแม่ เราทุกคน
การรักษาด้วยสเต็มเซลล์ ได้กลายเป็นหนึ่งในนวัตกรรมทางการ
“ตับ” คืออวัยวะที่เป็นเหมือนฮีโร่เงียบของร่
เช็กลิสต์ก่อนตัดสินใจ… การตัดสินใจ เก็บสเต็มเซลล์
โรคที่เกี่ยวข้องกับระบบประสาทและสมอง เช่น พาร์กินสัน อั
ในยุคที่เต็มไปด้วยมลภาวะ เชื้อโรคอุบัติใหม่ และความเครี
การเดินทางสู่การเป็นคุณพ่อคุณแม่สำหรับหลายๆ คู
ในยุคที่ข้อมูลข่าวสารล้นทะลักสเต็มเซลล์
ก้าวข้ามขีดจำกัดของร่างกายมนุษย์ ร่างกายมนุษย์คือกลไกอั

 EN
EN